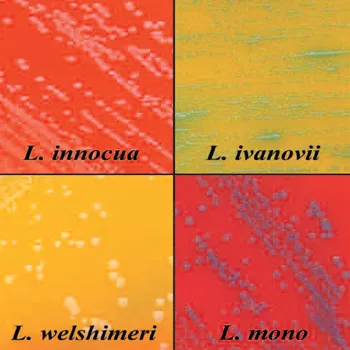

Color-Coded Colonies Make Test Reading a Breeze
Listeria contamination is an issue that can never totally be conquered. It lingers in drains and in soil, dormant and waiting to attack when you least expect it, and the results can be catastrophic. Fever, vomiting, stillbirths and death can all occur when the pathogen strain of this bacterium is ingested.
Often, companies will test their food production lines for indicator organisms. These are organisms that, if present on plant environment surfaces, can indicate poor sanitization conditions. Listeria spp. are used as indicators of the pathogenic Listeria monocytogenes.
The best defense against Listeria contamination is vigilant testing. And the faster or more easily you can get test results, the sooner you can get products out the door.
Traditional testing methods for Listeria take days for test confirmation and the results are less than crystal clear. PALCAM media, for example, requires 48 hours for preenrichment, and microorganisms other than Listeria, such as staphylococci or enterococci, may grow. The time spent waiting for test results and deciphering what they mean delays product ship dates, diminishing product shelf-life and adding to overall manufacturing costs.
The industry needs a clearer and more rapid indicator of Listeria, to test finished products and to evaluate the overall environment. Bio-Rad Laboratories, a leading rapid microbiology diagnostic test kit company based in Hercules, CA, has responded with its RAPID’L.Mono test, a selective chromogenic medium for detection and enumeration of Listeria spp. in food products for animal and human consumption and in the environment. It returns results in half the time than traditional cultures but still gives microbiologists the hands-on experience of seeing the colonies on the plate. With RAPID’L.Mono, enumeration of colonies by species is possible, allowing the user to gather data on the efficiency of their surface cleaning procedures.
Apple Orchard Project Proves Veracity of The Rapid’L.Mono Test
But is it as reliable? The answer is yes, according to Carol Ziel, university research associate for Iowa State University, Ames, IA. Last year, Ziel set out to find Listeria in an apple orchard and decided to evaluate the accuracy of the Bio-Rad tool as an environmental test for Listeria. She sampled raw cider, processed cider, apples, processing equipment and soil to be sure she was covering all of the obvious environmental hot spots. All of the samples came back free of Listeria monocytogenes, says Ziel.
Ziel knew the RAPID’L.Mono test was faster and easier to read than traditional Listeria tests using PALCAM agar, but she wanted to prove that the results were just as reliable. When she didn’t find any L. monocytogenes in her orchard samples, Ziel spiked a new set from the same environmental sources, testing some with PALCAM and some with the RAPID’L.Mono test. The differences, she says, were quickly evident.
The PALCAM culture took about a day longer to develop, and in the test results the colonies were dark in color with no clear visual indicator of species. This lack of clarity required Ziel to randomly pick colonies off the sample to test their species. The rapid test from Bio-Rad, on the other hand, color codes its colonies.
Listeria monocytogenes produces blue colonies (PIPLC positive) without yellow halo (xylose negative); whereas Listeria ivanovii produces greenish-blue colonies (PIPLC positive) with yellow halo (xylose positive) and other Listeria spp. colonies are white (PIPLC negative). This distinctive color-coding process means that even as the culture is developing the user can see exactly what is there. And because there is only a 24-hour preenrichment, results come faster.
“The spiked cider sample was beautiful,” Ziel says. “It was crisp and clean with white and colored colonies. It was a picture-perfect plate.”
Similarly the spiked soil sample tested with the RAPID’L.Mono was far easier to read than the PALCAM test. “Even though the number of colonies on the plate were too numerous to count, you could see the blue colonies pop out from the others,” Ziel says. She was able to easily pick those out and go back to identify them. “Even if you have 200 colonies, the color on the RAPID’L.Mono culture makes them very easy to see.”
Ziel sees the Bio-Rad test as a great benefit to labs, not just for end products, but for hygiene testing. “For Hazard Analysis and Critical Control Points (HACCP), it’s a great plate that gives you quantifiable proof of what you’ve got,” she says. “It’s much easier to use.”
“This test has real potential for environmental testing,” Ziel adds, noting that the ability to get rapid test results is key to successful sanitation efforts in the food processing facility. “The old method was like looking for a needle in a haystack.”
bio-rad.com
Looking for quick answers on food safety topics?
Try Ask FSM, our new smart AI search tool.
Ask FSM →








